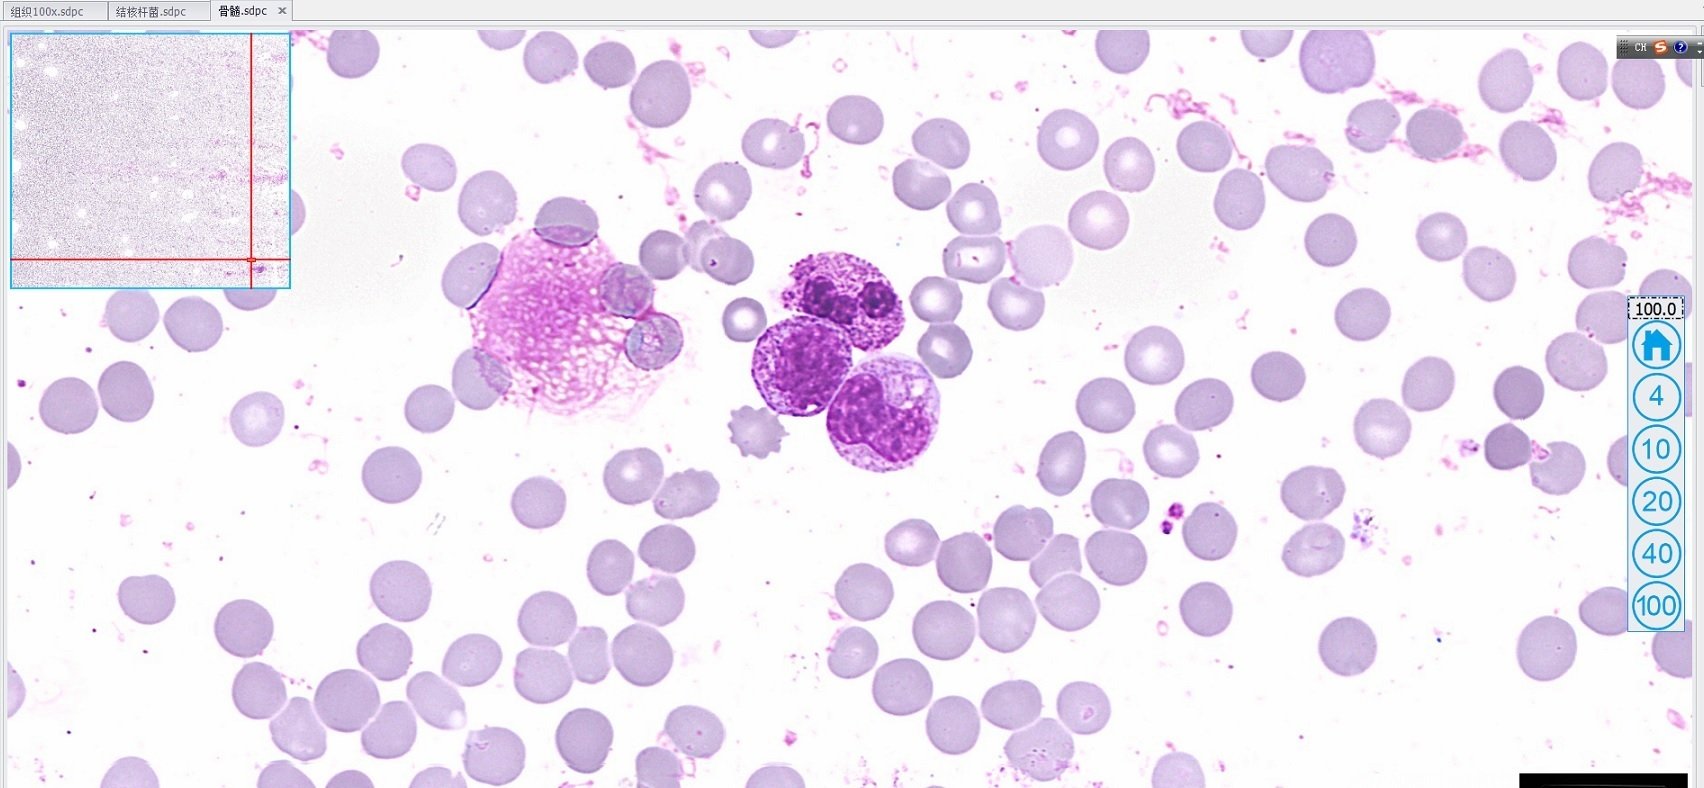
全自動切片掃描儀2

產品名稱: 切片掃描儀|全自動切片掃描儀
產品類型: 臨時分類
產品型號: 全自動切片掃描儀
發布時間: 2020-09-18
- 切片掃描儀|全自動切片掃描儀產品描述
全自動切片掃描儀玻片掃描影像分析系統玻片掃描影像分析系統在病理掃描上的應用。

自主研發設計的玻片掃描影像分析系統具有靈活的物鏡配置、全自動上載玻片、超大尺寸掃描;可以將數萬張病理切片圖片無縫隙拼接成一張完整的切片,
智能生成一張全視野的數字化切片,可以數字化、完整、永久存儲玻片的信息。
專家可以從一張宏觀圖像瀏覽,然后放到到任意位置任意倍率,觀察切片細節。

全自動切片掃描儀產品特點
更清晰:SlideScan能夠快速無縫隙的掃描整個玻片,它具有高掃描質量和分辨率,2倍為0.35um/pixel;40倍為0.175um/pixel。
更快速:玻片掃描影像分析系統有獨特的掃描方式,20倍下掃描速度為50s,40倍下掃描速度為75s。(15*15mm樣品區域,更高掃描速度可以定制)。
更全面:玻片掃描影像分析系統擁有單片以及高通量(525片)版本。并具有真實的雙物鏡系統,物鏡可選配。
更精準:納米位移控制的閉環壓電陶瓷電機控制Z軸。快速精準對焦。
以上系統為玻片掃描影像分析系統配套軟件使用掃描控制軟件,可實現對玻片樣品的準確定位,實時逐點掃描并成像,實時圖像拼接并存儲。
掃描過程全程自動,操作簡單,快捷方便。使用閱讀讀片軟件,用于打開數字病理切片查看并對其進行編輯。該軟件支持圖片格式:sdpc、
jpg、bmp、tif、png、rgb888原始圖像格式等。支持繪圖、添加文本、撤銷、截圖、保存信息等功能。支持定點縮放、整圖拖動,響應速度高。
全自動切片掃描儀主要應用領域
全自動切片掃描儀應用領域-病理切片數字化
數字化信息更易于整理和瀏覽
可長期保存,并節省存放玻片空間
病理診斷方便讀片
全自動切片掃描儀應用領域-遠程病理會診
不受時間空間影響,可網上遠程會診
全自動切片掃描儀應用領域-讀片會研討
與病理信息系統結合,實現真正的數字病理信息化,可多人網上討論。
全自動切片掃描儀應用領域-病理課程教學
將組織玻片制作成數字切片,應用于組織學教學。
全自動切片掃描儀應用領域-人工智能(AI)病理診斷
解決細胞學醫生不足的問題
解決閱片效率問題
解決閱片醫生水平參差不齊的問題
全自動切片掃描儀應用領域-核心技術
玻片掃描影像分析系統擁有全倍數物鏡配置,能夠手動裝載單片以及全自動識別玻片倉最大裝片為525片。
并具有真實的雙物鏡系統,物鏡可選配,標準配置:20XOLYMPUSUPLF物鏡、
40XOLYMPUSUPLFLN物鏡可自由切換。并有納米位移控制的冰環壓電陶瓷電機控制Z軸。
對焦機構為壓電納米物鏡平臺,總行程>150um,小信號(20um行程,定位時間<40ms),分辨率10nm;快速精準聚焦定位。切片掃描儀多少錢?
不同品牌不同廠家的切片掃描儀,定價都是不一樣的,考慮到功能,價格都是不一樣的,大家在采購之前,可以比較從功能,性價比方面多多入手。






- 其他產品